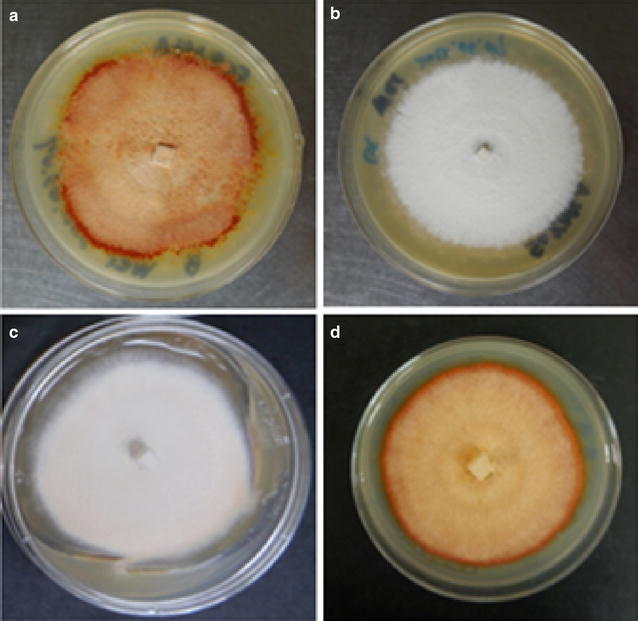
圖 1

普通牛樟芝和白牛樟芝主要三萜類化合物的物候變化
摘要
圖表
圖1
8週齡牛樟芝形態…
圖1
8週齡牛樟芝形態90 × 20 mm 培養皿上的肉桂…
圖1 8 週齡牛樟芝在90 × 20 mm 培養皿中的形態,含有50 ml 50% MEA 培養基。 aA.黑暗條件下的肉桂菌株 B(常規); bA.黑暗條件下的肉桂菌株 G(天然存在的白色); cA.連續藍光輻射(誘導白光)下的肉桂菌株 B; dA。肉桂菌株 B 在 6 週藍光輻射和 2 週黑暗條件下
圖2
牛樟芝生長曲線…
圖2
菌株B暗處理的牛樟芝生長曲線(紅A.…
圖2 菌株B(紅A.C.)和G(白A.C.)暗處理以及藍光處理B菌株的牛樟芝生長曲線
圖3
乙酸乙酯的TLC 分析...
圖3
乙酸乙酯萃取物的TLC 分析2、4、6 和 8 週齡…
圖 3 對 2、4、6 和 8 週齡牛樟芝 TLC 平板的乙酸乙酯萃取物進行 TLC 分析。和Ehmann 試劑染色下表達,由左到右a 常規A. cinnamomea;b 天然存在的白色A. cinnamomeac<。白色肉桂粉d 8 週齡肉桂粉菌株B (B)、菌株G (G) 和藍光誘導菌株B 的薄層層析比較 ( BB)
圖4
乙酸乙酯的HPLC 曲線…
圖4
乙酸乙酯萃取物的HPLC曲線8 週齡牛樟芝 B 株…
圖 4 8 週齡牛樟芝 B 株的乙酸乙酯萃取物在黑暗條件下的 HPLC 譜,顯示 1 個 Antcin K 2 Antcin C;酸C; 5 詹奎酸B; 7 詹奎酸A; 9 脫氫乙二酸
圖 5
8 週的 HPLC 曲線比較...
圖 5
HPLC 曲線比較8 週齡牛樟芝菌株B ( a ),…
圖5 8 週齡牛樟芝菌株B (a) 的HPLC 光譜比較,黑暗條件下的G (< b>b) 和藍光輻射下的菌株B (c) 編號的峰表示圖4 所示的10 種主要三萜類化合物。